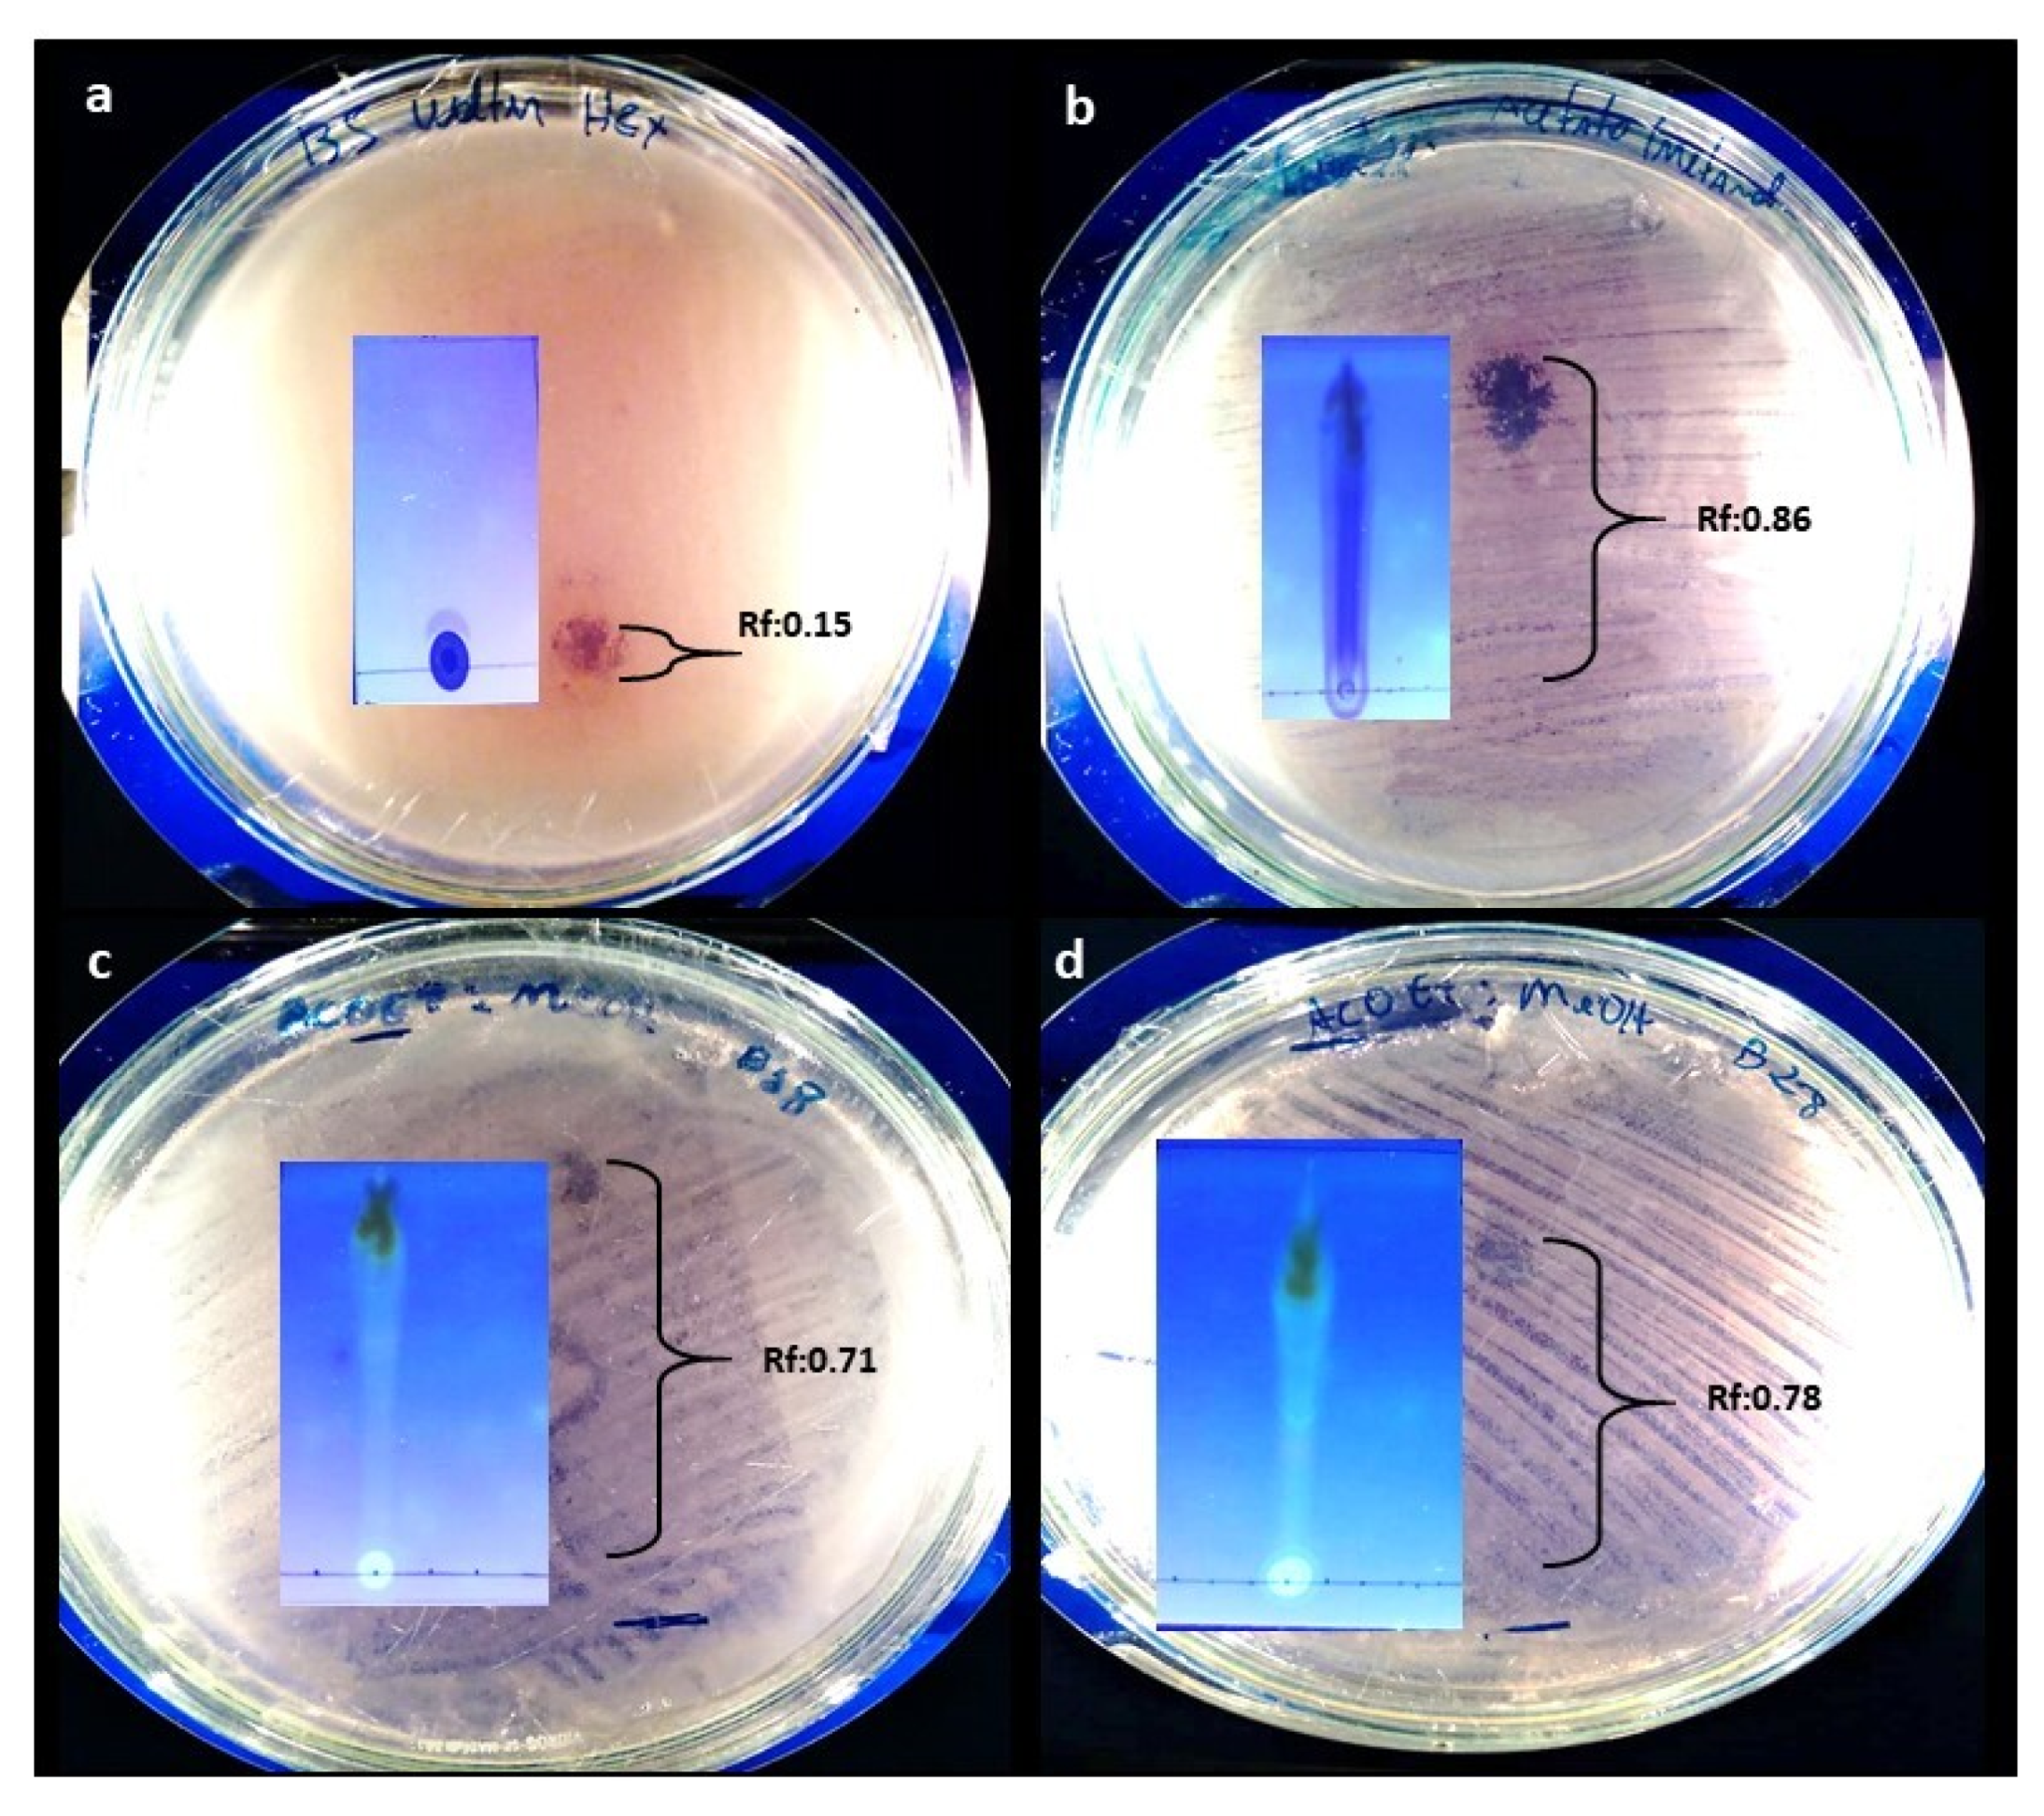
Antibiotics 12 00027 g0a2 Antibiotics 12 00027 g0a2

Antimicrobial Potential of Metabolites in Fungal Strains Isolated from a Polluted Stream: Annulohypoxylon stygium WL1B5 Produces Metabolites against Extended-Spectrum Beta-Lactamase-Positive Escherichia coli
Abstract
1. Introduction
2. Results
2.1. Collection Sites
2.2. Fungal Isolates
2.3. Production of Antibacterial Substances by the Fungal Isolates
Minimum Inhibitory Concentration—MIC
2.4. In Vitro Cytotoxicity Assay
2.5. TLC and Contact Bioautography
2.6. LC-MS/MS Analysis
3. Discussion
4. Materials and Methods
4.1. Sample Collection
4.2. Isolation of Fungi from the Polluted Water
4.3. Molecular Fungal Identification
4.4. Fungal Cultivation to Assess Secondary Metabolite Production
4.5. Preparation of Extracts
4.6. Assessment of Antimicrobial Activity of Fungal Metabolites on E. coli Strains Applying the Well Plate Method
Minimum Inhibitory Concentration (MIC)
4.7. Cytotoxicity Bioassays
4.8. Thin Layer Chromatography (TLC)
4.9. Contact Bioautography
4.10. Liquid Chromatography-Mass Spectrometry (LC-MS/MS)
5. Conclusions
Author Contributions
Funding
Institutional Review Board Statement
Informed Consent Statement
Data Availability Statement
Conflicts of Interest
Appendix A

References
- WHO. New Report Calls for Urgent Action to Avert Antimicrobial Resistance Crisis. 2019. Available online: https://www.who.int/news/item/29-04-2019-new-report-calls-for-urgent-action-to-avert-antimicrobial-resistance-crisis (accessed on 5 October 2022).
- Khan, A.; William, R.M.; Cesar, A.A. Mechanisms of antimicrobial resistance among hospital-associated pathogens. Expert Rev. Anti-Infect. Ther. 2018, 16, 269–287. [Google Scholar] [CrossRef] [PubMed]
- Nolte, O. Antimicrobial resistance in the 21st century: A multifaceted challenge. Protein Peptide Lett. 2014, 21, 330–335. [Google Scholar] [CrossRef] [PubMed]
- Blackwell, M. The fungi: 1, 2, 3… 5.1 million species? Am. J. Bot. 2011, 98, 426–438. [Google Scholar] [CrossRef] [PubMed]
- Smith, H.A. Production of Antimicrobials and Antioxidants from Filamentous Fungi. Doctoral Thesis, National University of Ireland Maynooth, Kildare, Ireland, 2014. Available online: http://mural.maynoothuniversity.ie/5802/ (accessed on 10 October 2022).
- Svahn, K.S.; Göransson, U.; El-Seedi, H.; Bohlin, L.; Larsson, D.G.J.; Olsen, B.; Chryssanthou, E. Antimicrobial activity of filamentous fungi isolated from highly antibiotic-contaminated river sediment. Infect. Ecol. Epidemiol. 2012, 2, 11591. [Google Scholar] [CrossRef]
- Omeike, S.O.; Kareem, S.O.; Lasisi, A.A. Potential antibiotic-producing fungal strains isolated from pharmaceutical waste sludge. Beni-Suef Univ. J. Basic Appl. Sci. 2019, 8, 1–7. [Google Scholar] [CrossRef]
- Tamura, K.; Nei, M. Estimation of the number of nucleotide substitutions in the control region of mitochondrial DNA in humans and chimpanzees. Mol. Biol. Evol. 1993, 10, 512–526. [Google Scholar]
- Souza Filho, E.A.; Alves, S.B.d.S.M.; Neves, R.K.R.; Batista, I.H.; Albuquerque, C.C.; Damasceno, S.B.; Nascimento, D.A. Estudo comparativo de aspectos físico-químicos entre águas da microbacia do mindu e igarapés sob influência antrópica na cidade de Manaus-AM. Braz. J. Dev. 2020, 6, 2419–2433. [Google Scholar] [CrossRef]
- Surup, F.; Wiebach, V.; Kuhnert, E.; Stadler, M. Truncaquinones A and B, asterriquinones from Annulohypoxylon truncatum. Tetrahedron Lett. 2016, 57, 2183–2185. [Google Scholar] [CrossRef]
- Honório, A.E. Avaliação química e biológica de fungos endofíticos associados às algas marinhas Acanthophora spicifera, Dichotomaria marginata e Sargassum vulgare. Doctoral Thesis, Universidade Estadual Paulista, São Paulo, Brazil, 2018. Available online: https://repositorio.unesp.br/handle/11449/180427 (accessed on 10 October 2022).
- Medina, R.P.; Araujo, A.R.; Andersen, R.J.; Soares, M.A.; Silva, F.D.A.; Silva, D.H. Aromatic compounds produced by endophytic fungi isolated from red alga Asparagopsis taxiformis - Falkenbergia stage. Nat. Prod. Res. 2018, 3, 443–446. [Google Scholar] [CrossRef]
- Moura, S.S.T. Avaliação da atividade antimicrobiana de fungos endofíticos isolados de plantas no Brasil contra patógenos humanos. Doctoral Thesis, Universidade Federal de Santa Catarina, Florianopolis, Brazil, 2020. [Google Scholar]
- Zhai, M.M.; Li, J.; Jiang, C.X.; Hou, Y.; Shi, Y.P.; Di, D.L.; Zhang, J.W.; Wu, Q.X. Isolation of Secondary Metabolites from the Soil-Derived Fungus Clonostachys rosea YRS-06, a Biological Control Agent, and Evaluation of Antibacterial Activity. J. Agric. Food Chem. 2016, 61, 2298–2306. [Google Scholar] [CrossRef]
- Dos Santos Dias, A.C.; Couzinet-Mossion, A.; Ruiz, N.; Lakhdar, F.; Etahiri, S.; Bertrand, S.; Ory, L.; Roussakis, C.; Pouchus, Y.F.; Nazih, E.H.; et al. Steroids from marine-derived fungi: Evaluation of antiproliferative and antimicrobial activities of eburicol. Mar. Drugs 2019, 17, 372. [Google Scholar] [CrossRef]
- Han, P.; Zhang, X.; Xu, D.; Zhang, B.; Lai, D.; Zhou, L. Metabolites from Clonostachys fungi and their biological activities. J. Fungi 2020, 6, 229. [Google Scholar] [CrossRef] [PubMed]
- Cheng, M.J. Secondary metabolites from the endophytic fungos Annulohypoxylon stygium BCRC 34024. Chem. Nat. Compd. 2014, 50, 237–241. [Google Scholar] [CrossRef]
- Gao, S.; Tian, W.J.; Liao, Z.J.; Wang, G.H.; Zeng, D.Q.; Liu, X.Z.; Wang, X.Y.; Zhou, H.; Chen, H.F.; Lin, T.; et al. Chemical Constituents from Endophytic Fungus Annulohypoxylon cf. stygium in Leaves of Anoectochilus roxburghii. Chem. Biodivers. 2020, 17, 200424. [Google Scholar] [CrossRef] [PubMed]
- Abdel-Wahab, N.M.; Harwoko, H.; Müller, W.E.; Hamacher, A.; Kassack, M.U.; Fouad, M.A.; Proksch, P. Cyclic heptapeptides from the soil-derived fungus Clonostachys rosea. Bioorg. Med. Chem. 2019, 27, 3954–3959. [Google Scholar] [CrossRef]
- Sofian, F.F.; Suzuki, T.; Supratman, U.; Harneti, D.; Maharani, R.; Salam, S.; Abdullah, F.F.; Koseki, T.; Tanaka, K.; Kimura, K.; et al. Cochlioquinone derivatives produced by coculture of endophytes, Clonostachys rosea and Nectria pseudotrichia. Fitoterapia 2021, 155, 105056. [Google Scholar] [CrossRef]
- Kamisuki, S.; Ishimaru, C.; Onoda, K.; Kuriyama, I.; Ida, N.; Sugawara, F.; Yoshida, H.; Mizushina, Y. Nodulisporol and Nodulisporone, novel specific inhibitors of human DNA polymerase λ from a fungus, Nodulisporium sp. Bioorg. Med. Chem. 2007, 15, 3109–3114. [Google Scholar] [CrossRef]
- Hayasaka, S.; Koseki, T.; Murayama, T.; Kwon, E.; Shiono, Y. Phenylisobenzofuranones from Fungicolous Nodulisporium sp. SH-1. Zeitschrift für Naturforsch B 2011, 66, 961–964. [Google Scholar] [CrossRef]
- Wang, Q.; Wang, H.; Xie, M. Antibacterial mechanism of soybean isoflavone on staphylococcus aureus. Arch. Microbiol. 2010, 192, 893–898. [Google Scholar] [CrossRef]
- Singhvi, M.S.; Zinjarde, S.S. Production of pharmaceutically important genistein and daidzein from soybean flour extract by using β-glucosidase derived from Penicillium janthinellum NCIM 1171. Process. Biochem. 2020, 97, 183–190. [Google Scholar] [CrossRef]
- Dang, H.; Kong, Q.; Winchester, W.; Wan, X.; Lei, Y.; Zhang, H.; Zhao, Y.; Liu, X.; Xu, B.B.; Zhang, B.; et al. Isolation, Identification and Pathogenic Effects of Trichoderma spp. from Auricularia auricula. Res. Sq. 2022; (preprint). [Google Scholar]
- Xuan, Q.C.; Huang, R.; Miao, C.P.; Chen, Y.W.; Zhai, Y.Z.; Song, F.; Wang, T.; Wu, S. Secondary Metabolites of Endophytic Fungus Trichoderma Sp. YM 311505 Of Azadirachta Indica. Chem. Nat. Compd. 2014, 50, 139–141. [Google Scholar] [CrossRef]
- Guo, L.; Wang, C.; Zhu, W.C.; Xu, F.Q. Bioassay-guided fractionation and identification of active substances from the fungus Aspergillus tubingensis against Vibrio anguillarum. Biotechnol. Biotechnol. Equip. 2016, 30, 602–606. [Google Scholar] [CrossRef][Green Version]
- Xie, Y.; Yang, W.; Tang, F.; Chen, X.; Ren, L. Antibacterial activities of flavonoids: Structure-activity relationship and mechanism. Curr. Med. Chem. 2015, 22, 132–149. [Google Scholar] [CrossRef] [PubMed]
- APHA. Standard Methods for the Examination of Water and Wastewater; APHA: Washingt, DC, USA, 2005. [Google Scholar]
- Ferrer, C.; Coloms, F.; Frasés, S.; Mullet, E.; Abad, J.L.; Alió, J.L. Detection and identification of fungal pathogens by PCR and by ITS2 and 5.8S ribosomal DNA typing in ocular infections. J. Clin. Microbiol. 2001, 39, 2873–2879. [Google Scholar] [CrossRef]
- White, T.J.; Bruns, T.; Lee, S.; Taylor, J. PCR Protocols: A Guide to Methods and Applications. In Amplification and Direct Sequencing of Fungal Ribosomal RNA Genes for Phylogenetics; Innis, N., Gelfand, D., Sninsky, J., White, T., Eds.; Academic Press: New York, NY, USA, 1990; pp. 315–322. [Google Scholar]
- O’donnell, K. The Fungal Holomorph; Mitotic, Meiotic and Pleomorphic Speciation in Fungal Systematic. In Fusarium and Its Near Relatives; CAB International: Wallingford, UK, 1993; pp. 225–233. [Google Scholar]
- Kumar, S.; Stecher, G.; Li, M.; Knyaz, C.; Tamura, K. MEGA X: Molecular evolutionary genetics analysis across computing platforms. Mol. Biol. Evol. 2018, 35, 1547–1549. [Google Scholar] [CrossRef]
- Lima, A.M.D.; Salem, J.I.; Souza, J.V.B.D.; Cortez, A.C.A.; Carvalho, C.M.; Chaves, F.C.M.; Junior, V.F.d. Effects of culture filtrates of endophytic fungi obtained from Piper aduncum L. on the growth of mycobacterium tuberculosis. Electron. J. Biotechnol. 2011, 14, 8. [Google Scholar]
- CLSI Document M02-A11; Performance Standards for Antimicrobial Disk Susceptibility Tests; Approved Standard—Eleventh Edition. Clinical and Laboratory Standards Institute: Wayne, PA, USA, 2012.
- CLSI document M07-A9; Performance Standards for Antimicrobial Disk Susceptibility Tests; Approved Standard—Eleventh Edition. Clinical and Laboratory Standards Institute: Wayne, PA, USA, 2012.
- Ahmed, S.A.; Gogal, J.R.; Walsh, J.E.A. A new rapid and simple non- radioactive assay to monitor and determine the proliferation of lymphocytes an alternative to [3H]thymidine incorporation assay. J. Immunol. Methods. 1994, 170, 211–224. [Google Scholar] [CrossRef]
- Khurram, M.; Khan, M.A.; Hameed, A.; Abbas, N.; Qayum, A.; Inayat, H. Antibacterial activities of Dodonaea viscosa using contact bioautography technique. Molecules 2009, 14, 1332–1341. [Google Scholar] [CrossRef]


| Limnological Parameters | Sampling Sites at Mindú Stream | |||
|---|---|---|---|---|
| Unit | Head Water | Central Point | Estuary | |
| Temperature | °C | 27 ± 0.1 | 27 ± 0.1 | 27 ± 0.1 |
| pH | - | 6.3 ± 0.1 | 7. 3 ± 0.2 | 6.1 ± 0.1 |
| Dissolved oxygen (DO) | (Sat) % | 3.2 ± 0.1 | 0.1 ± 0.1 | 0.1 ± 0.1 |
| Chemical oxygen demand O2 (Conc.) | mgO2/L | 57 ± 0.1 | 107 ± 0.2 | 151 ± 0.3 |
| Turbidity | NTU | 3.4 ± 0.2 | 3.9 ± 0.2 | 10 ± 0.3 |
| Eletric conductivity | µScm−1 | 0.4 ± 0.1 | 47.6 ± 0.4 | 106.8 ± 0.1 |
| Nitrate | mg/L | 0.1 ± 0.1 | 0.2 ± 0.1 | 2 ± 0.1 |
| Nitrite | mg/L | 0.1 ± 0.1 | 0.1 ± 0.1 | 0.2 ± 0.1 |
| Amonia | mg/L | 0.1 ± 0.1 | 0.2 ± 0.0 | 1.2 ± 0.1 |
| Total nitrogen | mg/L | 1.4 ± 0.1 | 2.4 ± 0.6 | 8.7 ± 0.1 |
| Total phosphorus | mg/L | 0.1 ± 0.1 | 0.2 ± 0.2 | 0.4 ± 0.1 |
| Orthophosphate | mg/L | 0.1 ± 0.1 | 0.1 ± 0.1 | 0.3 ± 0.1 |
| Sample Site | CFU/mL | Total Isolates | Genera | Number of Isolates by Genus |
|---|---|---|---|---|
| Head water (03 01′07.31″ S 59 55′84″ W) | 1.4 × 10 | 14 | Colletotrichum sp. Oidiodendrum sp. Mycelia sterilia | 1 1 12 |
| Central point (03 04′28.4″ S 59 58′57.7″ W) | 2.4 × 10 | 24 | Annulohypoxylon sp. Chloridium sp. Clonostachys sp. Oidiodendrum sp. Paecilomyces sp. Rodothorula sp. Trichoderma sp. Mycelia sterillia | 1 1 1 1 1 1 1 17 |
| Estuary (03 06′58.4″ S 60 02′01.5″ W) | 2.9 × 10 | 29 | Aspergillus sp. Clonostachys sp. Fusarium sp. Penicillium sp. Rodothorula sp. Trichoderma sp. Mycelia sterillia | 1 1 5 1 1 4 17 |
| Fungal Species | Zones of Inhibition (mm) | |||||
|---|---|---|---|---|---|---|
| Bacterial Strains | ||||||
| E. coli ATCC 25922 | E. coli NCTC 13353 | |||||
| Hex | EtOAc | CE | Hex | EtOAc | CE | |
| Annulohypoxylon stygium WL1B5 | - | 35.9 ± 0.1 | - | - | 14 ± 1.4 | 5.95 ± 0.1 |
| Colletotrichum fructicola WL3B9 | 7.9 ± 0.1 | 7.25 ± 0.4 | 6 mm | - | - | - |
| Clonostachys rosea WL5B18 | - | 19.8 ± 0.3 | 13.9 ± 0.1 | - | 4 ± 1.4 | - |
| Clonostachys rosea WL8B28 | 1 ± 1.4 | 13.15 ± 1.2 | 26.95 ± 0.1 | - | 8 ± 1.4 | 18.9 ± 0.1 |
| Trichoderma harzianum WL9B49 | - | 4.4 ± 0.8 | - | - | - | - |
| Positive control (amoxillin 50 µg/mL) | 20 mm | 0 mm | ||||
| Negative control (10% DMSO) | 0 mm | 0 mm | ||||
| Extract | Minimum Inhibitory Concentration of EtOAc Extracts (µg/mL) | ||
|---|---|---|---|
| Fungal Species and Strain Identity | Bacterial Strains | ||
| E. coli ATCC 25922 | E. coli NCTC 13353 | ||
| EtOAc | Annulohypoxylon stygium WL1B5 | 400 µg/mL | 400 µg/mL |
| Clonostachys rosea WL5B18 | 400 µg/mL | 400 µg/mL | |
| Clonostachys rosea WL8B28 | 400 µg/mL | 400 µg/mL | |
| Positive control | amoxillin (12.5 µg/mL) | ||
| Negative control | 10% DMSO | ||
| EtOAc Extract | Mobile Phase | Rf of Bands with Antimicrobial Activity |
|---|---|---|
| A. stygium WL1B5 | Hex (100%) | 0.15 |
| MeOH (100%) | 0.86 | |
| C. rosea WL5B18 | EtOAc/MeOH (1:1) | 0.71 |
| C. rosea WL8B28 | EtOAc/MeOH (1:1) | 0.78 |
Disclaimer/Publisher’s Note: The statements, opinions and data contained in all publications are solely those of the individual author(s) and contributor(s) and not of MDPI and/or the editor(s). MDPI and/or the editor(s) disclaim responsibility for any injury to people or property resulting from any ideas, methods, instructions or products referred to in the content. |
© 2022 by the authors. Licensee MDPI, Basel, Switzerland. This article is an open access article distributed under the terms and conditions of the Creative Commons Attribution (CC BY) license (https://creativecommons.org/licenses/by/4.0/).
Share and Cite
Segundo, W.O.P.F.; de Oliveira, R.S.; Lima, R.M.; Santiago, P.A.L.; de Oliveira, L.A.; Cortez, A.C.A.; Lima, E.S.; de Souza, É.S.; Frickmann, H.; de Souza, J.V.B. Antimicrobial Potential of Metabolites in Fungal Strains Isolated from a Polluted Stream: Annulohypoxylon stygium WL1B5 Produces Metabolites against Extended-Spectrum Beta-Lactamase-Positive Escherichia coli. Antibiotics 2023, 12, 27. https://doi.org/10.3390/antibiotics12010027
Segundo WOPF, de Oliveira RS, Lima RM, Santiago PAL, de Oliveira LA, Cortez ACA, Lima ES, de Souza ÉS, Frickmann H, de Souza JVB. Antimicrobial Potential of Metabolites in Fungal Strains Isolated from a Polluted Stream: Annulohypoxylon stygium WL1B5 Produces Metabolites against Extended-Spectrum Beta-Lactamase-Positive Escherichia coli. Antibiotics. 2023; 12(1):27. https://doi.org/10.3390/antibiotics12010027
Chicago/Turabian StyleSegundo, Walter Oliva Pinto Filho, Roberta Silva de Oliveira, Rildo Mendes Lima, Paulo Alexandre Lima Santiago, Luciana Aires de Oliveira, Ana Cláudia Alves Cortez, Emerson Silva Lima, Érica Simplício de Souza, Hagen Frickmann, and João Vicente Braga de Souza. 2023. "Antimicrobial Potential of Metabolites in Fungal Strains Isolated from a Polluted Stream: Annulohypoxylon stygium WL1B5 Produces Metabolites against Extended-Spectrum Beta-Lactamase-Positive Escherichia coli" Antibiotics 12, no. 1: 27. https://doi.org/10.3390/antibiotics12010027
APA StyleSegundo, W. O. P. F., de Oliveira, R. S., Lima, R. M., Santiago, P. A. L., de Oliveira, L. A., Cortez, A. C. A., Lima, E. S., de Souza, É. S., Frickmann, H., & de Souza, J. V. B. (2023). Antimicrobial Potential of Metabolites in Fungal Strains Isolated from a Polluted Stream: Annulohypoxylon stygium WL1B5 Produces Metabolites against Extended-Spectrum Beta-Lactamase-Positive Escherichia coli. Antibiotics, 12(1), 27. https://doi.org/10.3390/antibiotics12010027

